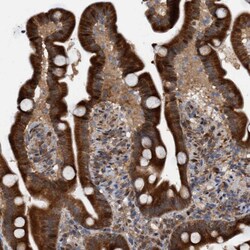
Invitrogen TANC2 Polyclonal Antibody 100 &mu;L; Unconjugated:Anticuerpos

Learn More
Invitrogen™ TANC2 Polyclonal Antibody
Rabbit Polyclonal Antibody
Marca: Invitrogen™ PA554744
Descripción
Immunogen sequence: DKTARTQQYP HLHQQNRTWA VSSVDTVLSP TSPGNLPQPE SFSPPSSISN IAFYNKTNNA QNGHLLEDDY YSPHGMLANG SRGDLLERVS QASSYPDVKV ARTLPVAQAY QDNLYRQLSR DSRQGQ Highest antigen sequence identity to the following orthologs: Mouse - 100%, Rat - 99%.

Especificaciones
| TANC2 | |
| Polyclonal | |
| Unconjugated | |
| TANC2 | |
| KIAA1148; KIAA1636; Protein TANC2; putative ankyrin-repeat containing protein; rolling pebbles homolog B; rols; ROLSA; TANC2; tetratricopeptide repeat, ankyrin repeat and coiled-coil containing 2; tetratricopeptide repeat, ankyrin repeat and coiled-coil domain-containing protein 2 | |
| Rabbit | |
| Antigen affinity chromatography | |
| RUO | |
| 26115 | |
| Store at 4°C short term. For long term storage, store at -20°C, avoiding freeze/thaw cycles. | |
| Liquid |
| Immunohistochemistry (Paraffin), Immunocytochemistry | |
| 0.4 mg/mL | |
| PBS with 40% glycerol and 0.02% sodium azide; pH 7.2 | |
| Q9HCD6 | |
| TANC2 | |
| Recombinant protein corresponding to Human TANC2. Recombinant protein control fragment (Product #RP-93400). | |
| 100 μL | |
| Primary | |
| Human | |
| Antibody | |
| IgG |
Al hacer clic en Enviar, acepta que Fisher Scientific se ponga en contacto con usted en relación con los comentarios que ha proporcionado en este formulario. No compartiremos su información para ningún otro fin. Toda la información de contacto proporcionada se mantendrá de acuerdo con nuestra Política de Privacidad. Política de privacidad.